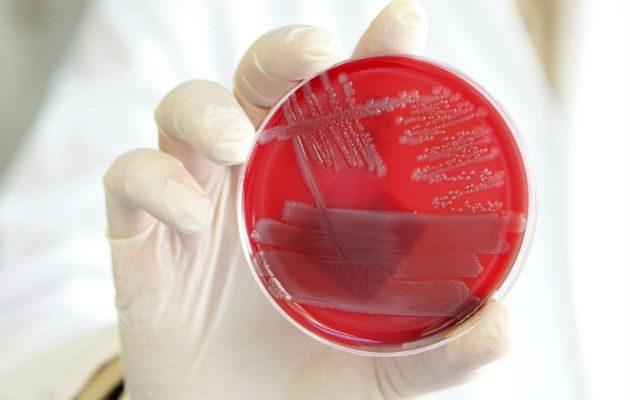

Muere una mujer en Florida tras contraer la bacteria come-carne en una playa
- Miami / EFE
Lynn Fleming, de Ellenton (Florida), murió el miércoles 26 de junio en un hospital, donde estaba conectada a una máquina tras haber sufrido dos accidentes cardiovasculares y una infección generalizada.
La familia de la mujer fallecida quiere que su muerte sirva para divulgar el peligro que representa la fascitis necrosante.
Una mujer que se hizo un corte en la pierna mientras paseaba por una playa de Florida murió dos semanas después a causa de la infección causada por una bacteria conocida como "come-carne", informaron medios locales este sábado.
Agresiva bacteria "come carne" casi mata a una menor de edad en playa de Floridahttps://t.co/IakZakSN1D
— Ahora Noticias (@ahoranoticiasAN) 29 de junio de 2019
Lynn Fleming, de Ellenton (Florida), murió el miércoles 26 de junio en un hospital, donde estaba conectada a una máquina tras haber sufrido dos accidentes cardiovasculares y una infección generalizada, informaron el canal Fox 13 su hijo Wade y su nuera, Traci, que estuvieron junto a ella en sus últimos días de vida.
La familia de la mujer fallecida quiere que su muerte sirva para divulgar el peligro que representa la fascitis necrosante, una infección bacteriana rara que se propaga por el cuerpo rápidamente y puede causar la muerte, si no se trata inmediatamente.
La bacteria "come-carne" como se conoce popularmente suele estar en aguas cálidas y ataca a personas que se bañan con una herida abierta.
Según los Centros de Prevención y Control de Enfermedades (CDC), una de cada tres personas que contrae la fascitis necrosante muere.
Desde 2010 se han diagnosticado en Estados Unidos entre 700 y 1.200 casos al año de fascitis necrosante, pero la cifra real es seguramente mayor, según los CDC.
La niña se despertó después de pasar un día jugando en una playa de Destin (Florida) con un dolor terrible y una inflamación detrás de una rodilla, tuvo que ser operada de emergencia al regresar a Indiana y hasta ahora ha tenido tres cirugías, según CNN.
En principio Fleming y su familia no le dieron demasiada importancia al pequeño corte que la mujer se hizo en una pierna durante un paseo en playa Coquina, en la isla Anna Maria, en la costa oeste de Florida.
VEA ATAMBIÉN Dos muertos por ola de calor en España y 10 mil hectáreas quemadas por incendio forestal
Dos días después la mujer al ver que tenía la pierna hinchada y enrojecida y fiebre fue al médico, que le dio una vacuna contra el tétanos y le recetó unos antibióticos. Al día siguiente fue encontrada inconsciente en su casa y llevada a un hospital, relataron al canal televisivo sus familiares.
En el hospital se comprobó que tenía fascistis necrosante y fue intervenida varias veces en la pierna herida. Estando ingresada sufrió dos ataques y una sepsis, según relataron sus familiares.
"Fue parecido a lo que uno ve en las películas. No puedo creer que ocurriera de verdad. Todo paso muy rápido", dijo Wade Fleming al canal televisivo.
CNN informó esta semana de otro caso de bacteria "come-carne" en una playa de Florida, del que fue víctima Kylei Brown, de 12 años, que viajó con su familia desde Indiana a pasar las vacaciones.



Para comentar debes registrarte y completar los datos generales.